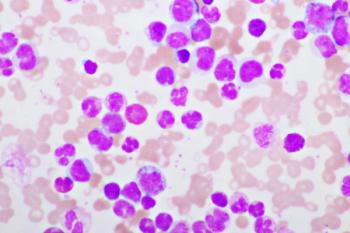

Hematology
Latest News

Latest Videos

CME Content
More News

Mikkael A. Sekeres, MD, of Sylvester Comprehensive Cancer Center, University of Miami, discussed data supporting the FDA approval of treosulfan as part of conditioning for allogeneic hematopoeitic stem cell transplantation (allo-HSCT).

The CELESTIAL-301 trial evaluating SynKIR-310, a novel chimeric antigen receptor T-cell therapy, has dosed its first patient with relapsed/refractory B-cell non-Hodgkin lymphoma (B-NHL).

Extranodal non-Hodgkin lymphoma (NHL) makes up over one-third of NHL cases, yet remains understudied and in need of deeper research considerations.

Serum soluble interleukin-2 receptor (sIL-2R) levels have been a great diagnostic tool for non-Hodgkin lymphoma (NHL) and could provide further benefits for distinguishing soft-tissue NHL from other soft tissue tumors.

Bispecific antibodies have altered the multiple myeloma (MM) treatment landscape, but some practices still lack enough familiarity with these therapeutics to deliver them in outpatient settings.

The FDA approved treosulfan in combination with fludarabine as preparation for allogeneic hematopoietic stem cell transplantation (allo-HSCT) in adult and pediatric patients with acute myeloid leukemia (AML) or myelodysplastic syndrome (MDS).

Infection risk remains a prominent clinical concern for patients with multiple myeloma (MM), even with the advent of modern, novel therapies.

The study demonstrated a poor prognosis overall for patients with acute myeloid leukemia (AML) who were previously treated with hypomethylating agents (HMAs) for myeloid neoplasms such as myelodysplastic syndromes.

Experts stress that persons wanting to donate blood should not stop any medications they are on, with some deferrals being permanent and others temporary.

This meta-analysis sheds more light on the beneficial impact of multiple melanoma (MM) treatments and the predictive value of minimal residual disease (MRD) status for patient prognoses.

Here are 5 things individuals should know about the powerful impact of blood donation and the benefits becoming a donor can have for patients in need.

Patients with multiple myeloma (MM) can experience diminished immune responses during prolonged treatment; however, mRNA vaccines could bolster immunity in this vulnerable population.

A study demonstrated that pre-transplant measurable residual disease (MRD) status is a strong prognostic factor for overall survival, disease-free survival, and relapse risk in patients with AML and MDS undergoing allogeneic stem cell transplantation.

A new study evaluating the quadratic phenotypic optimization platform shows it can accurately predict personalized drug combination sensitivities, paving the way for improved treatment strategies and outcomes in acute myeloid leukemia (AML).

The 66th American Society of Hematology (ASH) Annual Meeting & Exposition took place December 7-10, 2024, in San Diego, California; the 2025 meeting is currently scheduled to take place in Orlando, Florida, December 6-9.

Through interviews and articles infused with expert insight, progress against this cancer that develops in the bone marrow was showcased.

Secondary immunodeficiency disease (SID) status was associated with significantly higher risk for severe bacterial infections in adult patients with chronic lymphocytic leukemia (CLL)/small lymphocytic lymphoma (SLL).

A national survey of Canadian hematologists reveals gaps and variability in supportive care strategies for older adults with myelodysplastic syndromes (MDS) and acute myeloid leukemia (AML), emphasizing the need for evidence-based guidelines.

Findings from a phase 2 trial show that luspatercept effectively improves anemia in patients with lower-risk myelodysplastic syndromes (MDS), enabling them to delay or prevent transfusion dependence while maintaining a favorable safety profile.

The expert knowledge presented at this year’s International Myeloma Society (IMS) annual meeting focused on minimal residual disease testing and status, defining and treating high-risk disease, CEPHEUS trial findings, and an investigational off-the-shelf chimeric antigen receptor T-cell therapy.

Conventional parameters for risk stratification prognosis for patients with low-risk myelodysplastic neoplasms, especially bone marrow blast percentage, drop their clinical significance once molecular lesions are included in prognostic scores.
Long-term data support the safety and efficacy of venetoclax (Venclexta) and obinutuzumab (Gazyva) in chronic lymphocytic leukemia (CLL), though questions remain about which patients would benefit most from the regimen.

Despite found associations, due to small sample sizes the researchers suggest readers interpret their findings with caution.

The FDA approval marks the first oral solution indicated for patients with different forms of leukemia.

In the most recent update to the National Comprehensive Cancer Network (NCCN) guidelines for treating patients who have multiple myeloma, a quadruplet regimen became the preferred first-line treatment option for transplant-eligible and -ineligible patients.